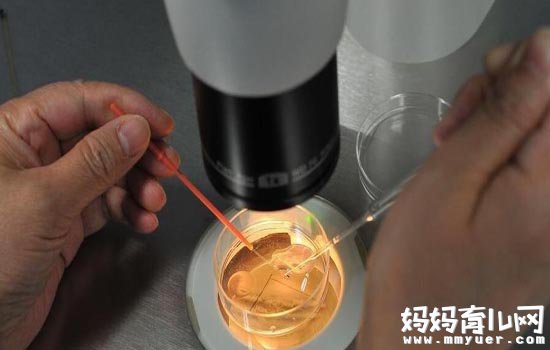

试管婴儿是用于治疗不孕不育症的一种常用方法,很多不孕不育的夫妻选择做试管婴儿成功怀孕生下了健康的宝宝。
做试管婴儿不是一个简单的事情,一是流程比较繁杂,有很多环节和步骤,二是需要夫妻双方有一个强大的内心,在检测中有可能指标不理想,此时千万不要灰心,调整心态,自己选择的路再难也要坚持下去。
我们知道,怀孕本来就是女方比较受罪,做试管婴儿也不例外,这篇文章就讲述了试管婴儿取卵痛苦吗,试管婴儿取卵后的注意事项。

揭秘试管婴儿取卵疼吗
试管婴儿取卵疼吗
试管婴儿是将女性体内的卵子取出,同时也要将男性的精子取出,然后将两者放置到培养液内使两者发生受精,然后再将发育的胚胎移植到母体的子宫内,而这种方法也就是试管婴儿法。而对于试管婴儿取卵大家最想了解的就是试管婴儿取卵疼吗?
专家介绍,进行试管婴儿是在B超下进行的,它是通过将一种特殊的针,也就是取卵针,通过阴道而穿到成熟的卵泡内,这样就可以取出卵子。而这样的过程都是在静脉的麻醉下进行的,所以不会产生疼痛,女性们不必担心。
但是要注意,为了手术的成功率,为了女性的身体健康,进行试管婴儿必须要到正规的医院。另外,如果夫妻计划采取这样的方法来怀孕,那就要做好心理准备,该方法的价格也是比较贵的。而且进行手术也是有一定的风险性的,所以一定要慎重。(下页:取卵后的注意事项)
试管婴儿取卵后注意事项
试管婴儿是用于治疗不孕不育症的一种常用方法,很多的患者在试管婴儿帮助下,生育了健康的宝宝。而为了试管婴儿能够成功,在取卵前后应当注意一些问题。那试管婴儿取卵后有哪些注意事项需要了解?
1、若用阴道取卵,当天及隔天会有少许褐色出血。此乃正常,因手术时需灌入二氧化碳,待气体完全吸收,需2—3天,则涨痛消失。
揭秘试管婴儿取卵疼吗
2、取卵之后,一定要保持伤口处的干净,不需要拆线,只有在第三天将胶布撕下即可。
3、当医生把胚胎移植到女性的子宫后,医生会告诉你如何服用药物、打针及何时回来抽血,看有无怀孕。
4、女性取卵之后,如果发现有血压降低或者是心跳加快,脸色苍白,小便困难,发烧等症状,一定要及时到医院进行治疗。
5、当伤口疼痛时,可按医生的指导服用药物。
小编的话
一般来说,试管婴儿取卵是要打麻药的,不会有明显的痛感;但也有的医院不给打麻药,这就需要忍耐一下了,不过为了能有一个健康的宝宝,这一点痛苦又算得了什么呢?取卵后要注意保持伤口处干净,注意饮食,不吃生冷的食物。
| 点赞 | 没用 | 路过 |












正在加载中... 






